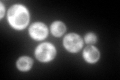
YAL035W
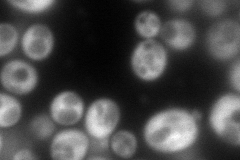
YAL035W
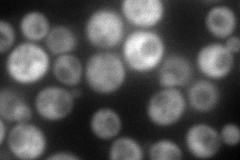
YAL035W
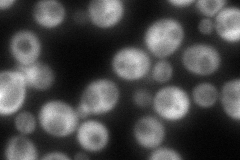
YAL035W
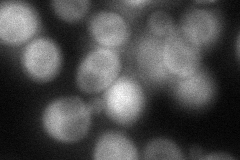
YAL035W

View description
GTPase, required for general translation initiation by promoting Met-tRNAiMet binding to ribosomes and ribosomal subunit joining; homolog of bacterial IF2
Localization:
Intensity:
Fold change:
Significance:
-
C’ GFP library in SD
cytosol282.66 -
N' NOP1pr-GFP in SD
cytosol228.864 -
N' TEF2pr-mCherry in SD
cytosol174.84 -
N' NATIVEpr-GFP in SD
cytosol160.501 -
N' TEF2pr-VC and Cyto-VN in SD
cytosol73.2946 -
C’ GFP library in SD+DTT

cytosol311.41.1No -
C’ GFP library in SD+H2O2

cytosol311.971.1No -
C’ GFP library in Starvation Media

cytosol167.860.59No -
C’ GFP library on the background of Pup2-DaMP

cytosol -
C’ GFP library on the background of CCT mutant

cytosol314.3281.11199No
